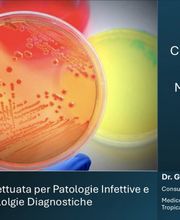
Gallery Cliente

Allianz Bank Financial Advisors SPA
Consulenza finanziaria
Viale Sandro Pertini 33, 43044 CollecchioPatologia
+393408909599 (Telefono)
Esperienze : Azienda Ospedaliero Università di Parma ( da 2022 al 2025) Formazione Iniziale Il mio percorso nasce da una profonda passione per le scienze, coltivata fin dai tempi del Liceo Scientifico e ponendo le basi per la mia futura carriera medica. Percorso Accademico Ho conseguito la laurea in Medicina e Chirurgia presso lUniversità degli Studi di Parma. Durante il percorso universitario, ho svolto numerosi tirocini clinici approfondendo le malattie infettive. La mia tesi di laurea affronta il tema della Colonizzazione e infezione da Enterobacteriaceae MDR in pazienti trapiantati renali. Specializzazione e Approfondimento Nel 2021 ho intrapreso la specializzazione in Malattie Infettive e Tropicali. In quattro intensi anni, ho studiato in profondità : patologie infettive, metodologie diagnostiche e i trattamenti innovativi, collaborando con il reparto di Microbiologia. Il mio interesse per l Antimicrobial Stewardship mi ha portato a partecipare come relatore a un corso di aggiornamento sullemocoltura, tema centrale della mia tesi di specializzazione, conseguita con lode Feb, 2025. Attività di Ricerca e Contributo Scientifico Ho partecipato a progetti di ricerca, pubblicato articoli su temi di grande attualità, quali Sars-CoV-2, carcinoma epatocellulare (HCC) e infezioni batteriche, consolidando un approccio clinico rigoroso, fondato su evidenze scientifiche e aggiornamento continuo. Impegno Professionale La mia formazione e il percorso accademico testimoniano un impegno costante vero la formazione. Ogni paziente è valutato con attenzione, la decisione terapeutica basata su solide evidenze per unassistenza sanitaria di altissimo livello.

Viale Sandro Pertini, 37, 43044 Collecchio
Consulenza finanziaria
Viale Sandro Pertini 33, 43044 CollecchioNegozio di abbigliamento · Moda · Vendita al dettaglio
Viale Sandro Pertini 41, 43044 CollecchioFisioterapia · Medico · Oculista
Viale Sandro Pertini 37, 43044 Collecchio